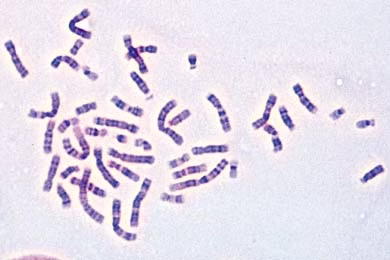

Download & Support
Unser Angebot richtet sich nur an Institutionen, Bildungseinrichtungen und autorisierte Vertragshändler. Kein Verkauf an Privatpersonen und nicht autorisierte Wiederverkäufer.
HINWEIS: Bitte beachten Sie, dass wir keine Chemikalien an Privatpersonen verkaufen. Lt. ChemVerbotsV dürfen wir Chemikalien nur an autorisierte Wiederverkäufer und öffentliche Forschungs-, Untersuchungs- und Lehranstalten abgeben.
Die angegebenen Preise und Angebote gelten nur innerhalb Deutschlands und nur für Webshop-Bestellungen. Änderungen und Irrtümer vorbehalten.
Wir verwenden Cookies und ähnliche Technologien auf unserer Website und verarbeiten personenbezogene Daten von Besucher:innen (z.B. IP-Adresse), um z.B. Inhalte und Anzeigen zu personalisieren, Medien von Drittanbietern einzubinden oder Zugriffe auf unsere Website zu analysieren. Die Datenverarbeitung erfolgt erst durch gesetzte Cookies. Wir teilen Daten mit Dritten, die wir in den Einstellungen benennen.
Die Zustimmung kann erteilt oder abgelehnt werden. Sie haben das Recht, nicht einzuwilligen und die Einwilligung zu einem späteren Zeitpunkt zu ändern oder zu widerrufen. Weitere Informationen finden Sie in unserer Datenschutzerklärung.